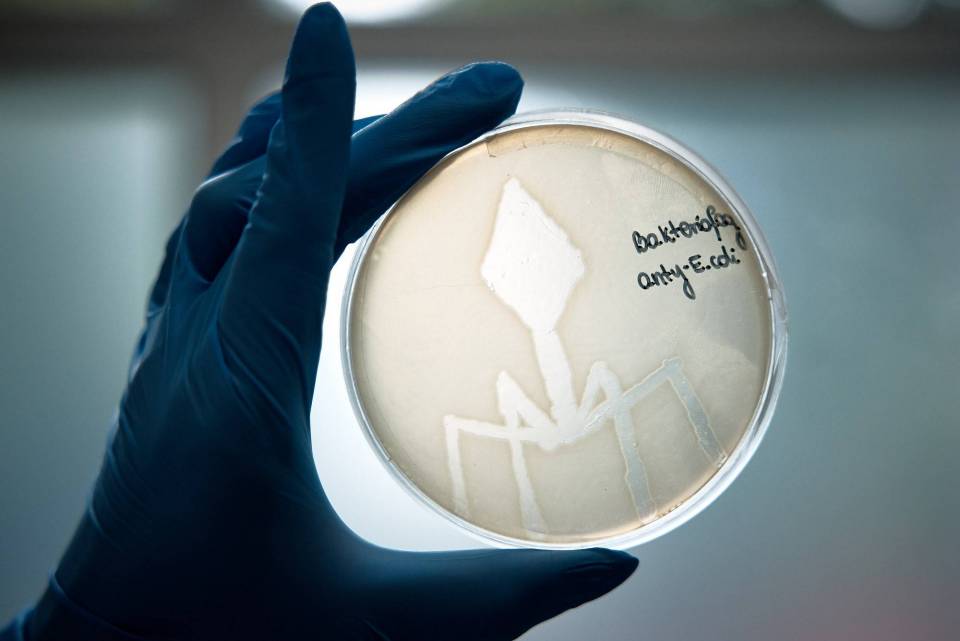

Najważniejsze wideo w epa24

Funduszowy Maj – cykl darmowych wydarzeń organizowanych w całym województwie łódzkim
Liczba osób, które zobaczyły to wideo97 167 wyświetlenia
Dożynki Województwa Łódzkiego 2025
Liczba osób, które zobaczyły to wideo716 289 wyświetlenia
Takiego wideo jeszcze nie widzieliście. Obejrzyjcie do końca
Liczba osób, które zobaczyły to wideo401 657 wyświetlenia
Mistrzostwa w sporcie pożarniczym w Grabowie
Liczba osób, które zobaczyły to wideo395 391 wyświetlenia
Pożar gazociągu w Gałkowie Dużym
Liczba osób, które zobaczyły to wideo388 912 wyświetlenia
W Bratoszewicach odbyły się kolejne Targi Rolne “Agrotechnika”
Liczba osób, które zobaczyły to wideo413 038 wyświetlenia
Sławomir Mentzen spotkał się z mieszkańcami regionu
Liczba osób, które zobaczyły to wideo162 706 wyświetlenia
Duża akcja policji w Łódzkiem. Zatrzymano blisko 100 przestępców!
Liczba osób, które zobaczyły to wideo465 445 wyświetlenia
Strażacy uratowali psa, który wpadł do 15-metrowej studni
Liczba osób, które zobaczyły to wideo155 343 wyświetlenia
"Adwentowy kalendarz życzliwości i pozytywnego myślenia"
Liczba osób, które zobaczyły to wideo390 343 wyświetlenia
W Zgierzu odbyła się gala sportów walki federacji Gunners Fight Night
Liczba osób, które zobaczyły to wideo201 815 wyświetlenia
Wielki sukces polskich strażaków w Holandii! Zdobyli złoto i brąz Mistrzostw Świata
Liczba osób, które zobaczyły to wideo381 220 wyświetlenia![Lekarze ze szpitala w Sieradzu wycięli pacjentowi 52-centymetrowy guz [DRASTYCZNE NAGRANIE]](/components/com_allvideoshare/assets/images/play.png)
Lekarze ze szpitala w Sieradzu wycięli pacjentowi 52-centymetrowy guz [DRASTYCZNE NAGRANIE]
Liczba osób, które zobaczyły to wideo332 551 wyświetlenia
Niezwykłe znaleziska podczas przebudowy ulic. Wszystkie przedmioty trafiły do...
Liczba osób, które zobaczyły to wideo407 127 wyświetlenia
W Tumie wręczono kolejne Nagrody im. Benedykta Polaka
Liczba osób, które zobaczyły to wideo336 918 wyświetlenia
Dożynki Gminy Daszyna
Liczba osób, które zobaczyły to wideo527 498 wyświetlenia
Województwo Łódzkie - rusza nowy program dla osób, które cierpią na bóle i choroby kręgosłupa, pleców oraz stawów
Liczba osób, które zobaczyły to wideo385 578 wyświetlenia
Dożynki Wojewódzkie 2024 w Spale
Liczba osób, które zobaczyły to wideo521 544 wyświetlenia
Potężny pożar zakładu w Żłobnicy
Liczba osób, które zobaczyły to wideo148 845 wyświetlenia
Bełchatów gospodarzem mistrzostw świata w nordic walking! Na trasy wyjdzie ponad 800 zawodników z 21 krajów
Liczba osób, które zobaczyły to wideo324 475 wyświetlenia
Poznaj Pana Bogusława z RGE "Żyj zdrowo"
Liczba osób, które zobaczyły to wideo322 845 wyświetlenia
Strzelanina w Łęczycy - nie żyje 45-letni mężczyzna
Liczba osób, które zobaczyły to wideo714 116 wyświetlenia
Dożynki Wojewódzkie - Marszałek Joanna Skrzydlewska zapowiada wielkie wydarzenie
Liczba osób, które zobaczyły to wideo426 154 wyświetlenia